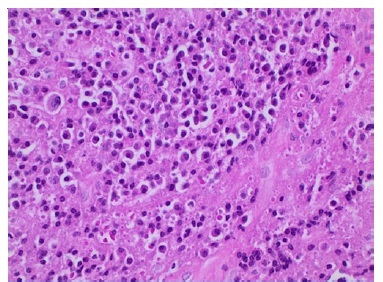

Introdução
O mieloma múltiplo (MM) é uma neoplasia maligna originada dos plasmócitos, que são derivados da medula óssea.1,2 Essas células produzem e segregam proteínas monoclonais no sangue, que têm uma sequência de aminoácidos e estrutura proteica anormal. Acredita-se que represente cerca de 10% das malignidades hematológicas. Apresenta maior prevalência em pacientes idosos, embora os pacientes jovens possam também ser afectados.3,4
Os sinais e sintomas mais comuns são: anemia, dor óssea, fadiga e infecções.5 As manifestações na região maxilofacial são incomuns, mas podem acontecer em algum momento da evolução da doença, tais como parestesia, mobilidade dentária, hemorragia gengival e ulceração.6,7 Imagiologicamente é uma lesão osteolítica, uni ou multilocular, que pode aparecer em qualquer região dos ossos gnáticos, inclusive associada ao ápice dentário.3,4 Dessa forma, o objetivo deste trabalho é descrever uma recidiva de mieloma múltiplo na mandíbula, que teve como principal característica o mimetismo de uma lesão endodôntica, com ênfase na importância do exame clínico bem executado, solicitação de exames complementares e anatomopatológico, para conclusão do diagnóstico.
Caso Clínico
Doente de 75 anos de idade, sexo feminino, leucoderma, procurou atendimento odontológico de urgência em fevereiro de 2019. Na anamnese, a paciente relatou como queixa principal dor de origem odontogénica, nos dentes 44 e 45, e aumento de volume doloroso na mandíbula do lado direito. A paciente negou trauma nos dentes envolvidos ou uso de aparelho ortodôntico, bem como patologias sistémicas dignas de nota.
No exame físico extraoral a paciente apresentou aumento de volume da região submandibular à direita, doloroso e avermelhado. O exame físico intraoral revelou, apagamento do sulco mandibular, além de lesão nodular, de superfície normocrómica e consistência endurecida, na região dos dentes 44 e 45, cujo primeiro pré-molar já possuía tratamento endodôntico, estando selado provisoriamente, e o segundo extensa restauração oclusal. Devido a queixa principal foi realizado teste de vitalidade pulpar, sendo constatada a necrose. As características clínicas foram muito semelhantes às de celulite de origem odontogénica. Portanto foi realizada abertura coronária, instrumentação, medicação intracanalar, antibioticoterapia sistémica e o selamento provisório do elemento 45.
Após três dias a paciente alegou aumento do volume e da intensidade da dor, período em que a tomografia computadorizada (TC) foi realizada.
A TC (Figuras 1, 2 e 3) revelou imagem hipodensa, ostelítica, de forma ovalada, promovendo rompimento da cortical vestibular, envolvendo o ápice dos dentes 44 e 45. Nesse momento, a paciente informou ter o diagnóstico de mieloma múltiplo há sete anos, sendo acompanhada por hematologista, sem apresentar sinais clínicos da manifestação da doença.

Figura 1 Reconstrucao axial de TC, evidenciando lesão hipodensa, osteolitica, causando rompimento da cortical vestibular e medindo 19 mm x 25 mm.

Figura 2 Reconstrução parassagital de TC. Observa-se lesão hipodensa e osteolítica envolvendo o ápice do dente 44
Além disso, não foi diagnosticada lesão mandibular no primeiro episódio. A paciente comunicou que omitiu o diagnóstico durante a anamnese por não acreditar ter relação com a odontalgia, e por ter feito exames laboratoriais e de imagem de corpo inteiro que descartaram qualquer sinal do mieloma, há cerca de trinta dias. Realizou-se punção aspirativa por agulha fina da área entumecida, não sendo observado presença de material líquido, sendo então optado pela realização de biopsia incisional (Figura 4), sob anestesia local, devido a necessidade de conclusão do diagnóstico. Durante o procedimento cirúrgico foi possível evidenciar um nódulo de superfície lisa, brilhante, avermelhada com estrias esbranquiçadas e friável a manipulação. A análise histopatológica (Figuras 5, 6 e 7), corada com Hematoxilina e Eosina, revelou proliferação de células de morfologia plasmocitóide, que apresentavam atipia, cromatina nuclear pontilhada e invasão do tecido conjuntivo, conferindo o laudo de mieloma múltiplo, sem necessidade de marcação imunohistoquímica, devido ao diagnóstico dessa lesão no passado.

Figura 5 Lencol de plasmocitos invadindo tecido conjuntivo fibroso (x100 - coloracao com Hematoxilina e Eosina)
Figura 6 Denso infiltrado de plasmocitos com núcleo grande e excentrico, nucleolo proeminente, moderado citoplasma e presenca de atipia (x200 - coloracao com Hematoxilina e Eosina)

Figura 7 Camada difusa e monotona de células plasmocitoides, apresentando cromatina nuclear pontilhada (x200 - coloracao com Hematoxilina e Eosina)
A doente foi encaminhada a centro de referência para tratamento, sendo realizada quimioterapia com Daratumumabe (1120mg), Bortezomibe (1,7mg) e Melfalano (2mg), além de radioterapia com dose de 45Gy. A paciente encontra-se estável e sem sinais de recidiva após 14 meses do início do tratamento.
A lesão mandibular encontra-se estável como pode se observar na TC de controlo (Figura 8).
Discussão e Conclusões
A gamopatia monoclonal de significado indeterminado (GMSI) é uma desordem rara assintomática associada a plasmócitos, sendo também um estágio pré-maligno para o MM. Afeta 3-4% da população com mais de 50 anos de idade e a quantidade de doentes afetados aumenta com a idade.8 Aproximadamente 80% dos pacientes diagnosticados com MM são precedidos da GMSI.3,9
A proliferação neoplásica de linfócitos B é conhecida como plasmocitoma ou MM. O primeiro é caracterizado pelo acometimento solitário, que pode ser intraósseo ou extramedular. No MM há disseminação dessa desordem.10 O MM é uma das neoplasias hematológicas mais comuns, com leve predileção pelo sexo masculino. A maioria dos casos acontece entre a 50 e 80 anos, com média de 60 anos, mas a manifestação em pacientes jovens é relatada. É caracterizada pela proliferação de plasmócitos na medula óssea e produção excessiva imunoglobulina monoclonal no sangue periférico.3,4,7Embora a etiologia permaneça incerta, certos agentes etiológicos, como radiação ionizante, exposição a produtos químicos, vírus e fatores genéticos, têm sido implicados.6,9,11 A paciente estudada estava no perfil epidemiológico de maior prevalência da doença.
As manifestações na região maxilofacial do MM são incomuns, e devido à variedade de sintomas o diagnóstico pode ser difícil.7 Geralmente as lesões apresentam predileção pela mandíbula em relação a maxila, provavelmente devido à maior hematopoiese.4 As principais manifestações clínicas são a expansão óssea, dor, mobilidade dentária, parestesia e macroglossia.7,9,12Radiograficamente é caracterizada pela formação de imagem osteolítica, de margem mal delimitada, podendo ser uni ou multilocular e ter aspeto de bolhas de sabão.4 A paciente estudada apresentou lesão dolorosa, osteolitica na mandíbula, de formato ovalado e com margens mal delimitadas, essas características estão de acordo os achados da literatura mundial.
A manifestação na região maxilofacial é bastante variada, e pode mimetizar radiograficamente lesões endodônticas,3 como pode ser observada na TC, a lesão osteolítica envolvendo o ápice dos dentes 44 e 45. Todavia, a odontalgia causada pelo MM é bastante incomum, sendo pouco relatada na literatura.6,10,12,13
A abordagem terapêutica para o MM depende da idade do paciente, saúde geral e comorbidades relacionadas. O tratamento do MM envolve radioterapia, quimioterapia, esteróides e transplante autólogo de células tronco. A resposta ao tratamento no MM é definida como uma redução parcial ou completa das proteínas séricas e diminuição significativa das células plasmáticas da medula óssea para menos de 5%. As lesões osteolíticas associadas podem ser tratadas com bifosfonatos.3,7Todavia, não se pode esquecer o risco de desenvolvimento de osteonecrose associada a esse grupo de medicamentos.14
O MM geralmente é considerado incurável e caracterizado por recidivas frequentes que requerem terapia.3 A taxa de sobrevida em cinco anos é 5,7%, portanto, o diagnóstico correto faz grande diferença no prognóstico desses doentes.15,16Dessa forma, podemos concluir que o exame clínico detalhado e a solicitação de exames complementares, quando necessário, foram fundamentais para conduta clínica correta. Esses procedimentos possibilitaram o diagnóstico de uma recidiva solitária de mieloma múltiplo na mandíbula. Devido ao prognóstico sombrio da doença, a conduta clínica foi fundamental, uma vez que, diagnosticou a recidiva no momento inicial, aumentando a sobrevida da paciente.

















